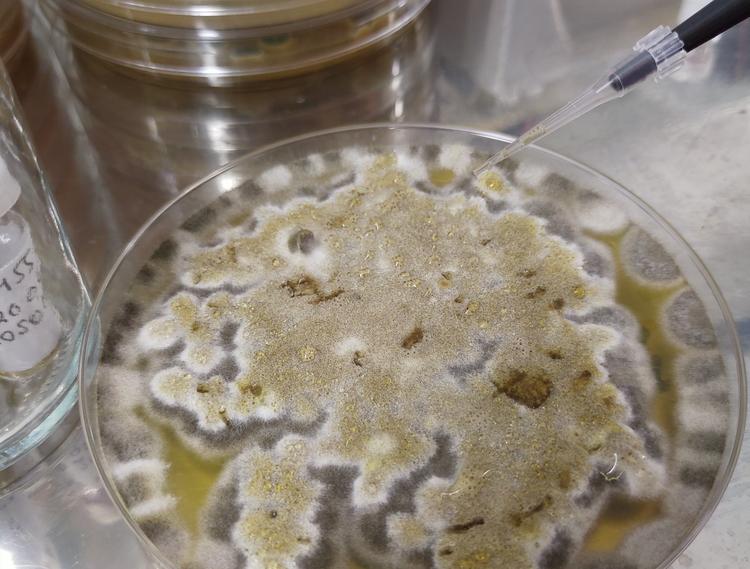

YRITTÄJÄ, tule mukaan omiesi pariin! Liity Yrittäjiin.
Tamperelaisyrittäjän vetämällä joukkorahoituskampanjalla haetaan euroja tutkimukseen, joka voisi ratkaista yhden ison kansanterveydellisen ongelman
Vaikka lääketieteessä ja teknologiassa otetaan jatkuvasti isoja harppauksia, sisäilman aiheuttamat oireilut ja sairastumiset eivät tunnu vähenevän. Pikemminkin sisäilmaongelmista tuntuu olevan vuosi vuodelta haittaa yhä useammalle. Ratkaisua ongelmaan haetaan tällä hetkellä joukkorahoituskampanjalla, joka kerää varoja aiheen tiimoilta tehtävään isoon tutkimukseen. Tamperelaisyrittäjän vetämä asiantuntijaryhmä uskoo, että siitä saatavat tulokset voivat muuttaa tyystin käsityksen kosteus- ja homealtistuksen vaikutuksista.
Kosteus- ja homevaurio (KOHO) 2021 -tutkimusryhmän primus motor, tamperelaisyrittäjä Elisa Aattela myöntää, että he ovat tarttuneet isoon ongelmaan, jonka ratkaisemisella voisi olla suurta hyötyä ja vaikutuksia. Arvioiden mukaan sisäilmaongelmat kun vaikuttavat jopa miljoonan suomalaisen elämään, mutta varsinaisissa syy–seuraussuhteissa on vielä selviteltävää.
Tiimi koostuu raskaan sarjan ammattilaisista
– Todellista sisäilmaongelman aiheuttajaa ei aina löydetä yleisesti käytetyillä tutkimusmenetelmillä. Siksi esimerkiksi havaittujen kosteusvaurioiden korjaaminen ei aina poista ongelmaa, vaan oireilu jatkuu myös tehtyjen korjausten jälkeen, Elisa Aattela tiivistää ongelman juurisyyt.
Aattela toimii tässä haastattelussa hankkeen puhemiehenä, mutta yksin hän ei suinkaan ole tutkimusta toteuttamassa. Mukana työryhmässä on niin teknisen puolen professoria, lääkäriä kuin alan tutkijoita. Samalla porukalla teetettiin jo viime vuonna pienemmän otannan tutkimus, jossa selviteltiin vaurioisten koulurakenteiden sisäilmanäytteitä ja sekä altistuneiden lasten että heidän vanhempiensa virtsanäytteitä. Tulokset olivat hyvin lupaavia, sillä sekä lasten virtsasta että rakennuksen homeista löytyi samoja homemyrkkyjä, jotka puolestaan puuttuivat tykkänään vanhemmilta otetuista näytteistä.

SISÄILMAONGELMAT KOSKETTAVAT todella isoa ryhmää. Jo vuonna 2012 THL arvioi määrän Suomessa olevan 800 000 ihmistä, ja Elisa Aattela uskoo luvun olevan tänä päivänä jo miljoonan tuntumassa. – Jatkuvalla syötöllähän meillä joudutaan tutkimaan niin päiväkoteja kuin koulujakin, joten ei tämä ongelma ainakaan vähentynyt ole. Valtava määrä lapsia meillä on koko ajan väistötiloissa, hän kertoo.
Näin tutkimus toteutettaisiin
Joukkorahoituksella haetaan nyt rahoitusta tutkimuksen jatko-osan toteuttamiseen. Sillä haluttaisiin vahvistaa aikaisemman, huomattavasti pienimuotoisemman tutkimuksen tulokset. Suunnitelma tästä on jo hyvin pitkälle laadittu. Ottaisimme mukaan kaksi koulua, vauriokoulun ja ongelmattoman verrokkikoulun sekä molemmista sata lasta. Idea on, että molemmista kohteista saadaan sisäilmanäytteet ja kaikkien tutkimukseen osallistuvien koululaisten veri- ja virtsanäytteet. Lisäksi jonkin verran otetaan näytteitä myös koululaisten vanhemmilta, jolloin meillä on jo kaikki vaativimmatkin tieteen kriteerit täyttävä tutkimus, yrittäjä selkeyttää. Tätä tutkimusta tehdään intohimosta ratkaista sisäilmaongelma.
Aikaa on marraskuuhun
Joukkorahoituskampanja käynnistyi 15. helmikuuta ja on voimassa 1. marraskuuta saakka. Halvimmillaan mukaan pääsee 20 eurolla. Joukkorahoitukseen rahoitusmuotona päädyttiin, koska nykyisessä rahoitusjärjestelmässä vaaditaan yliopistojen mukanaoloa ja meidän työryhmämme koostuu yksittäisistä yrittäjistä sekä alalla olevista asiantuntijoista, joilla on erityisosaamista pitkään alalla olleina. Työryhmämme tavoite on ratkaista ongelma ja saada uutta tietoa jaettua myös maailmalle. Tällainen tutkimusyhteistyö puuttuu kokonaan meidän nykyisestä järjestelmästämme. Näytteitä otetaan satoja sisäilmasta ja tutkimuksessa verrataan olemassa olevia tutkimusmenetelmiä uusiin. Ihmisistä otettavia eritenäytteitä tulee myös satoja.
– Erityisesti verinäytteiden tutkimukset kustantavat melkoisesti, sillä niihin tarvittavaa osaamista ei löytynyt Suomesta, vaan ne pitää lähettää tutkittaviksi Yhdysvaltoihin ja Keski-Eurooppaan, Aattela avaa. Nyt haettavan joukkorahoituksen kärkitavoite on saada sen verran näyttävät todisteet menetelmän toimivuudesta, että siitä tulisi standardi myös julkiselle sektorille.
– Nyt olemme siis hakemassa menetelmälle julkisuutta ja virallista hyväksyntää, jotta se saataisiin käyttöön myös julkiselle puolelle. Parhaimmillaan tässä puhutaan kansanterveyden kannalta merkittävästä tutkimuksesta, Aattela huomauttaa.
Teksti: Ville Kulmala
Kuvat: Elisa Aattela
Artikkeli on julkaistu ensimmäisen kerran Pirkanmaan Yrittäjä -lehdessä 8.6.2021